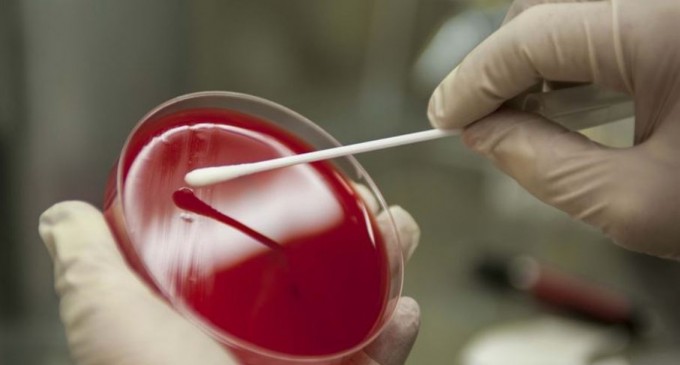
Marea Britanie și Roche spun că testele Covid pot detecta și noua tulpină a coronaviruslui – Coronavirus

România…Inteligența Artificială…Guvernul… - EDITORIAL
 de prof.dr. Daniel Mihai
de prof.dr. Daniel Mihai
Dacă nici acum nu vă vine să credeți, guvernul Dăncilă lucrează la strategia națională pentru Inteligența Artificială. Este inimaginabil, aproape de necrezut, dar elaborarea și ratificarea primei strategii naţionale în domeniul Inteligenţei Artificiale va fi o realitate.
Deseori,obișnuiți cu puțin din ceea ce ne tot oferă „din plin” viața aceasta, nu prea realizăm și nu prea știm să reacţionăm la acest soi de anunț oficial. Iar ceea ce este frapant vine de-acum înainte.
Da, stimabilelor și dumneavoastră onorați domni. Din moment ce a fost declarat „liber la Inteligența Artificială”, consecințele și desele implicații ne vor afecta destinele. Poate părea ceva de domeniul SF,dar tocmai ultimele evenimente au început să contrazică „scenariul.”
A trecut moda când mai auzeam de un nou studiu care descria savant implicațiile profunde pe care le au progresele din domeniul inteligenței artificiale. Iar, inevitabilul s-a pridus.Au căzut în derizoriu acele minți luminate, dimpreună cu toata adunarea numeroșilor experți, a think tankuri sau a celebritățilir din Silicon Valley care își dădeau cu presupsul că aplicațiile practice ale Inteligenței Artificiale urmează să ne schimbe viețile în moduri greu de imaginat.
Inteligenţa artificială este trecută de faza „copilăriei”. Acest lucru îl demonstrează unele experimente eşuate care au avut loc. Iar aici dau ca exemplu cazul „adolescentului” Tay al Microsoft, un robot bazat pe inteligenţă artificială care putea dialoga cu utilizatorii de Twitter. Acesta a devenit nazist în câteva ore, compania fiind nevoită să îl retragă. Incidentul a arătat limitările pe care le au maşinile, incapabile deocamdată să facă diferenţa între bine şi rău sau să dea dovadă de empatie.
Dar, ce anume împiedică pentru ca maşinile să ajungă la astfel de însuşiri umane?
Sunt destui semeni care se tem că inteligenţa artificială va fi folosită ca armă, de guverne sau grupări teroriste. Un astfel de sistem avansat, capabil să înveţe, ar putea să compromită orice sistem informatic şi să aibă acces la informaţii extrem de importante. Mai mult, ar putea lansa atacuri cu arme periculoase şi pot da naştere unui război devastator.
Iar acum, „onor” guvern al acestei colonii susţine cu o frenezie de nedescris această modă, dând dovada unui servilism exemplar! Oare cărui scopuri servește?
citeste in continuare